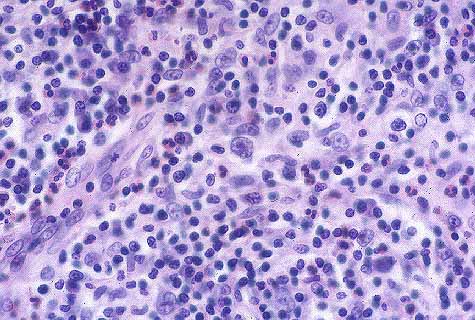
fig. 10
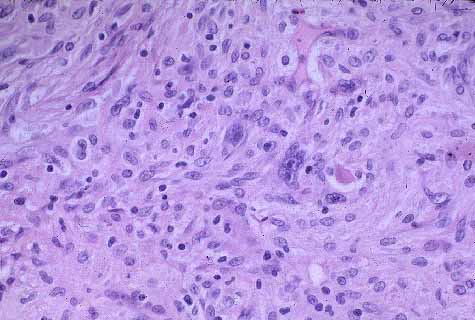
fig. 12

ComunicaciÛn
N∫ 003
ComunicaciÛn |
T.G.Miralles; M.V.Folgueras; M.P.Carrasco; C.Turiel; A.Astudillo.
 |
| Fig 9.- P.A.A.F de adenopatia del caso presentado. Fibroblastos-like y cÈlula de R-E.H&EX20. |
 |
| Fig 9a.- P.A.A.F perteneciente al caso .Area tÌpica de un LH con cÈlulas polilobadas, alguna c plasmatica y escasos eosinofilos.H&EX20. |
|
| Fig 10.- Aspecto histologico en el area con imagen tÌpica de LH en que se observan celulas de H junto con eosinofilos, plasmaticas y alg˙n fibroblasto.H&EX20. |
 |
| Fig 11.-Histologia perteneciente a ·rea de transiciÛn entre aspecto de LH y pseudosarcoma. H&EX20. |
|
| Fig 12.- Aspecto con abundantes cÈlulas de aspecto de fibroblastos, entre ellas observamos algunas cÈlulas de H.H&EX20. |
 |
| Fig 13. Presencia de cÈlulas CD15 positivas en el ·rea con aspecto fibroblastico.TinciÛn de Avidina Estreptoavidina X 40. |
 |
| Fig 14.- Aspecto histologico en que el linfoma presenta un patrona esteriforme que semeja un FHM. H&EX40. |